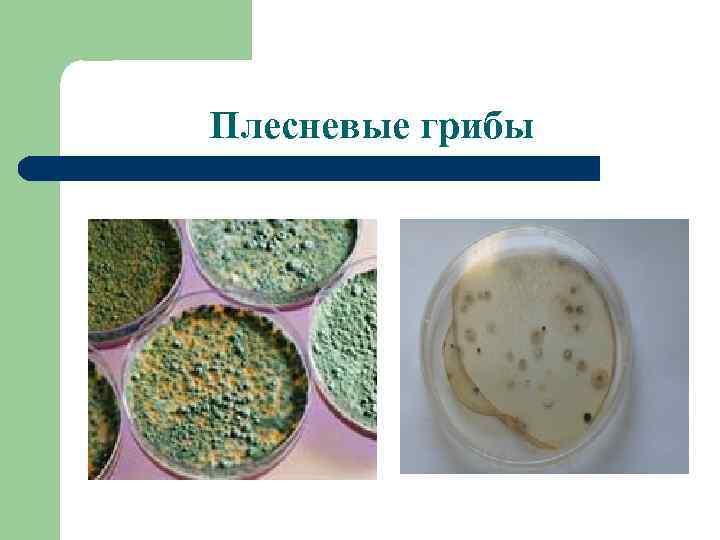
Плесневые грибы

Плесневые грибы презентация.ppt
- Количество слайдов: 13
 Нормативные документы l Сан. Пи. Н 2. 1. 3. 1375 -03 (для больниц, родильных домов и других лечебных стационаров) : Особо чистые (А), чистые (Б), условно чистые (В) помещения – 0 кое/м 3; грязные помещения (Г) – не нормируется. l Сан. Пи. Н 2. 1199 -03 (для парикмахерских, косметических, маникюрных, педикюрных, массажных кабинетов) : l до 20 кое/м 3. Методические указания по микробиологическому контролю в аптеках, № 3182 -84 от 29 декабря 1984 г (для аптек): асептический блок, стерилизационная, ассистентская, фасовочная, дефектарная, материальная – 0 кое/м 3, моечная – до 12 кое/м 3, зал обслуживания – до 20 кое/м 3.
Нормативные документы l Сан. Пи. Н 2. 1. 3. 1375 -03 (для больниц, родильных домов и других лечебных стационаров) : Особо чистые (А), чистые (Б), условно чистые (В) помещения – 0 кое/м 3; грязные помещения (Г) – не нормируется. l Сан. Пи. Н 2. 1199 -03 (для парикмахерских, косметических, маникюрных, педикюрных, массажных кабинетов) : l до 20 кое/м 3. Методические указания по микробиологическому контролю в аптеках, № 3182 -84 от 29 декабря 1984 г (для аптек): асептический блок, стерилизационная, ассистентская, фасовочная, дефектарная, материальная – 0 кое/м 3, моечная – до 12 кое/м 3, зал обслуживания – до 20 кое/м 3.
Плесневые грибы
Плесневые грибы
 Плесневые грибы рода Аspergillus Схематическое изображение Вид под микроскопом
Плесневые грибы рода Аspergillus Схематическое изображение Вид под микроскопом
 Плесневые грибы рода Аspergillus (вид под микроскопом)
Плесневые грибы рода Аspergillus (вид под микроскопом)
 Аэрозольный генератор PRO ULF (дезинфекция поверхностей через воздух)
Аэрозольный генератор PRO ULF (дезинфекция поверхностей через воздух)
 Дюльбак ДТБЛ l Концентрат для дезинфекции и предстерилизационной очистки l Жидкость темно-голубого цвета, без запаха, хорошо смешивается с водой l Действующее вещество: дидецилдиметиламмоний хлорид 4, 5% l р. Н концентрата 11, 0± 0, 5 l Форма выпуска: канистра 5 л, флакон 1 л l Срок годности концентрата: 3 года со дня выпуска
Дюльбак ДТБЛ l Концентрат для дезинфекции и предстерилизационной очистки l Жидкость темно-голубого цвета, без запаха, хорошо смешивается с водой l Действующее вещество: дидецилдиметиламмоний хлорид 4, 5% l р. Н концентрата 11, 0± 0, 5 l Форма выпуска: канистра 5 л, флакон 1 л l Срок годности концентрата: 3 года со дня выпуска
 Аэролайф (обеззараживание воздуха в присутствии людей)
Аэролайф (обеззараживание воздуха в присутствии людей)
 АЭРОЛАЙФ-Л Область применения Медицинские учреждения: l Операционные, предоперационные, родильные, детские палаты роддомов. l Перевязочные, комнаты стерилизации, палаты реанимационных отделений, вирусологические и бактериологические лаборатории, фармацевтические цеха. l Палаты, кабинеты врачей, помещения ЛПУ (туберкулезных больниц). Детские и дошкольные учреждения. Административные и офисные здания. Жилые дома.
АЭРОЛАЙФ-Л Область применения Медицинские учреждения: l Операционные, предоперационные, родильные, детские палаты роддомов. l Перевязочные, комнаты стерилизации, палаты реанимационных отделений, вирусологические и бактериологические лаборатории, фармацевтические цеха. l Палаты, кабинеты врачей, помещения ЛПУ (туберкулезных больниц). Детские и дошкольные учреждения. Административные и офисные здания. Жилые дома.
 АЭРОЛАЙФ-Л Принцип действия l l Принцип действия основан на технологии фотокаталитического окисления летучих органических соединений и любых патогенных организмов, находящихся в воздухе. В процессе фотокатализа все летучие органические соединения и органические вещества микроорганизмов не накапливаются на фотокаталитическом фильтре, а под действием ультрафиолетового излучения в присутствии фотокатализатора разлагаются на безвредные компоненты естественной воздушной среды.
АЭРОЛАЙФ-Л Принцип действия l l Принцип действия основан на технологии фотокаталитического окисления летучих органических соединений и любых патогенных организмов, находящихся в воздухе. В процессе фотокатализа все летучие органические соединения и органические вещества микроорганизмов не накапливаются на фотокаталитическом фильтре, а под действием ультрафиолетового излучения в присутствии фотокатализатора разлагаются на безвредные компоненты естественной воздушной среды.
 АЭРОЛАЙФ-Л Очистка и обеззараживание воздуха. Прибор чистит воздух от: l Выхлопных газов, угарного газа, окислов азота, фенолов, формальдегидов, озона, аммиака, сероводородов. l Токсичных органических соединений бытового и промышленного происхождения (хлоро- и кислородо содержащие углеводороды, эфиры, альдегиды и кетоны, ароматические и гетероциклические канцерогены. l Копоти, пыли, неприятных запахов. l Аллергенов различного происхождения. l Болезнетворных бактерий и вирусов (грипп, туберкулез, плесень, грибки).
АЭРОЛАЙФ-Л Очистка и обеззараживание воздуха. Прибор чистит воздух от: l Выхлопных газов, угарного газа, окислов азота, фенолов, формальдегидов, озона, аммиака, сероводородов. l Токсичных органических соединений бытового и промышленного происхождения (хлоро- и кислородо содержащие углеводороды, эфиры, альдегиды и кетоны, ароматические и гетероциклические канцерогены. l Копоти, пыли, неприятных запахов. l Аллергенов различного происхождения. l Болезнетворных бактерий и вирусов (грипп, туберкулез, плесень, грибки).
 Део-Антиплесень (Россия) l l l Жидкий концентрат для удаления плесени и мха на основе биоцидного компонента. Для использования в учреждениях различного профиля и в быту. Форма выпуска: флакон 1 л. Большие объемы упаковки возможны по желанию клиента. Санитарно-эпидемиологическое заключение: № 66. 01. 10. 238. П. 000849. 03. ТУ 2386 -004 -26433370 -2003.
Део-Антиплесень (Россия) l l l Жидкий концентрат для удаления плесени и мха на основе биоцидного компонента. Для использования в учреждениях различного профиля и в быту. Форма выпуска: флакон 1 л. Большие объемы упаковки возможны по желанию клиента. Санитарно-эпидемиологическое заключение: № 66. 01. 10. 238. П. 000849. 03. ТУ 2386 -004 -26433370 -2003.
 Део-Антиплесень Назначение l Уничтожение и предотвращение роста плесневых грибов, и удаление неприятных запахов на деревянных, кирпичных, оштукатуренных бетонных, керамических и других поверхностях.
Део-Антиплесень Назначение l Уничтожение и предотвращение роста плесневых грибов, и удаление неприятных запахов на деревянных, кирпичных, оштукатуренных бетонных, керамических и других поверхностях.
 Део-Антиплесень Назначение l Обработка поверхностей в местах с повышенной влажностью: ванные комнаты, погреба, подвалы, парники, гаражи.
Део-Антиплесень Назначение l Обработка поверхностей в местах с повышенной влажностью: ванные комнаты, погреба, подвалы, парники, гаражи.


